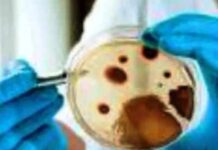
Black fungus cases rise in Andhra Pradesh

Vijayawada, April 05, 2023: The Prime Minister, Shri Narendra Modi has praised the achievement of AIIMS Mangalagiri, Andhra Pradesh for crossing 10 lakh outpatient consultations. Shri Modi also informed that in one of the recent Mann Ki Baat programmes, he had discussed this issue including interaction with a doctor and someone who has benefitted from tele-consultations.
Replying to the tweet by AIIMS Mangalagiri, Andhra Pradesh about 10 lakh outpatient consultations, the Prime Minister tweeted;
“A good achievement by the institution. In one of the recent #MannKiBaat programmes I had discussed this issue including interaction with a doctor and someone who has benefitted from tele-consultations.”